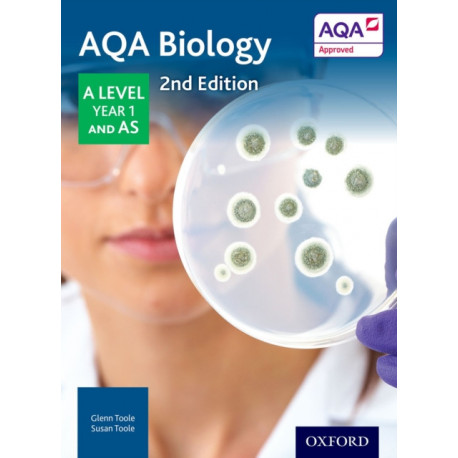
AQA Biology: A Level Year 1 and AS

Kurv
Vare
varer
(tom)
Ingen varer
Fastlægges senere
Forsendelse
0,- kr
I alt
AQA Biology: A Level Year 1 and AS
(Bog, Paperback / softback, Engelsk)
Forlag:
Oxford University Press
- Type: Bog
- Format: Paperback / softback
-
Sprog:
Engelsk

- ISBN-13: 9780198351764
- Se flere detaljer ▼
Beskrivelse
Fully revised and updated for the linear qualification, written and checked by curriculum and specification experts, this Student Book supports and extends students through the course while delivering the breadth, depth, and skills needed to succeed at A Level and beyond.
Læsernes anmeldelser (0)
Alle detaljer
| Forlag | Oxford University Press |
| Forfattere | Glenn Toole, Susan Toole |
| Type | Bog |
| Format | Paperback / softback |
| Sprog | Engelsk |
| Udgave | 2 Revised edition |
| Udgivelsesdato | 08-01-2015 |
| Første udgivelsesår | 2015 |
| Illustrationer | Colour |
| Originalsprog | United Kingdom |
| Sideantal | 328 |
| Indbinding | Paperback / softback |
| Forlag | Oxford University Press |
| Sideoplysninger | 328 pages, Colour |
| Mål | 265 x 196 x 13 |
| ISBN-13 / EAN-13 | 9780198351764 |

